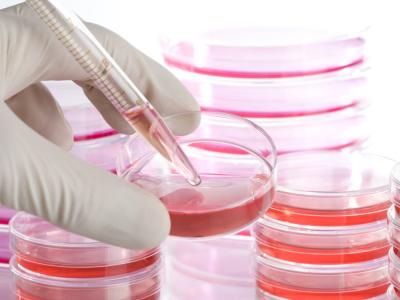

Avance médico Solución innovadora con células madre para las tendinopatías Fuente del artículo: https://www.lavanguardia.com/vida/salud/20180704/45607612951/solucion-innovadora-para-las-tendinopatias-con-celulas-madre.html Una investigación con células madre aporta esperanza para conseguir el primer tratamiento efectivo de una patología muy difícil de resolver Hay que admitirlo: pese a su […]
Adiós al Viagra: nueva terapia basada en células madre para tratar la disfunción eréctil
Adiós al Viagra: nueva terapia basada en células madre para tratar la disfunción eréctil La disfunción eréctil (DE) es la manifestación más común dentro del grupo de disfunciones sexuales masculinas, que se manifiesta en alrededor de un 8% de la […]
Catalunya ya regenera con células madre el cartílago con artrosis
El Banc de Sang desarrolla por primera vez en 2014 una terapia celular contra la enfermedad El producto ha sido experimentado con éxito en 15 pacientes con rodilla desgastada La investigación con un tipo de células madre que contiene la […]
¿Será niño o niña? Descubre las disparatadas formas que se usaban antes para averiguarlo
Métodos un tanto disparatados para averiguar el género del bebé Antes de que existiesen las ecografías, se recurrían a métodos un tanto disparatados para averiguar el género del bebé. Mezclar pis con bicarbonato o comer ajo, eran algunos de los […]
Implementan células madre para la regeneración de piel
Para brindar una mayor atención y calidad de vida, se consolida el programa de terapias con células madre en pacientes quemados en el Hospital Coromoto de Maracaibo con resultados positivos, tras la firma de un convenio con el Instituto Venezolano […]
Células madre dan esperanzas a los pacientes de esclerodermia
La esclerodermia es una grave enfermedad autoinmune que afecta alrededor de 2,5 millones de personas en el mundo. Según un reciente ensayo clínico un trasplante de células madre es más efectivo que el tratamiento médico actual para alargar la vida […]
Una bebé británica que nació con el corazón fuera del cuerpo sobrevive a tres cirugías
Una bebé británica que nació el mes pasado con el corazón fuera del cuerpo ha sobrevivido a tres operaciones en un hospital de Leicester, en el centro de Inglaterra, según informa la BBC. Vanellope Hope Wilkins vino al mundo el […]
Curan con células madre las fístulas anales de enfermos de Crohn
Un equipo multidisciplinar de la Unidad de Coloproctología del Hospital Universitario Virgen del Rocío de Sevilla ha conseguido curar con células madre las molestas y frecuentes fistulas anales que padecen los afectados por la enfermedad de Crohn. El ensayo clínico que ha permitido este avance ha contado […]
Células madre transgénicas salvan la vida a un ‘niño mariposa’
Los científicos han combinado células madre y terapia génica para reemplazar el 80% de su piel. Cuando una condición genética rara (epidermis bullosa o piel de mariposa) destruyó casi el 80% de la piel de un niño de 7 años, […]
Identifican las células madre clave para regenerar la sangre y el sistema inmune
Hallado un subtipo de células madre hematopoyéticas capaces de repoblar completamente la médula ósea y, por tanto, de regenerar tanto la sangre como el sistema inmune Las células madre hematopoyéticas son el tipo de células madre responsables de convertirse en […]